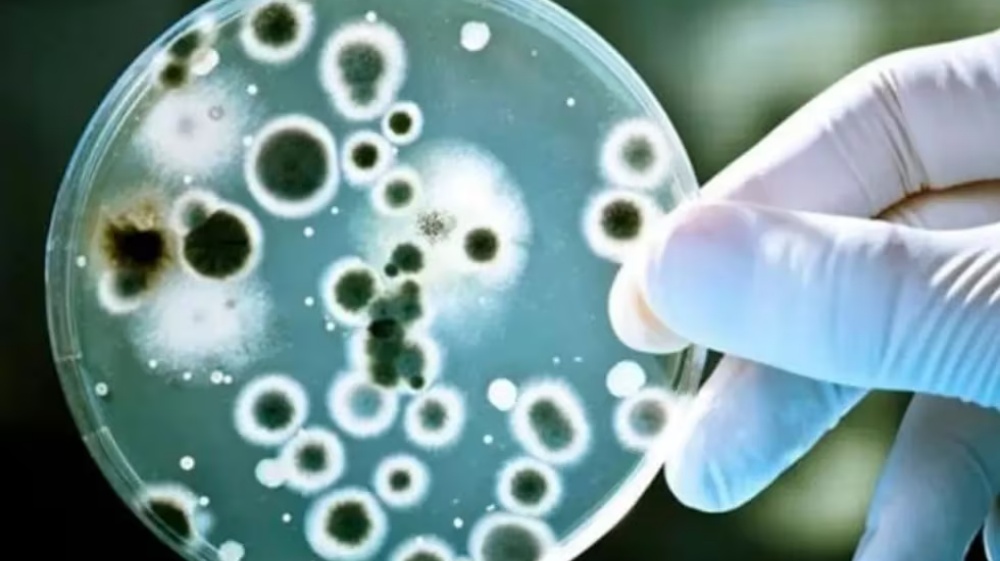

Nacionales
Francisco hablará ante los líderes de la COP28 en una visita de 38 horas a Dubai
En su paso que será del 1 al 3 de diciembre, el papa dará dos discursos en la cumbre climática y mantendrá "encuentros privados bilaterales" con los participantes....
En su paso que será del 1 al 3 de diciembre, el papa dará dos discursos en la cumbre climática y mantendrá "encuentros privados bilaterales" con los participantes.
Fuente: https://www.telam.com.ar/notas/202311/645937-francisco-lideres-cop28-visita-dubai.html